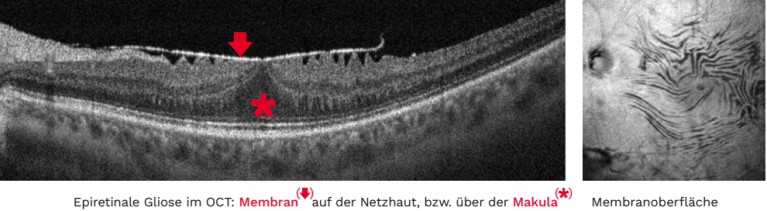

Bergman Clinics Augenklinik Universitätsallee
Parkallee 301 28213 Bremen +49 (0)421 5665-200 info.bremen@bergmanclinics.de Mehr Informationen

Zurück zur:

Unsere Netzhaut – das lichtempfindliche Gewebe im hinteren Bereich des Auges – ist entscheidend für unser Sehvermögen. Besonders im Zentrum, der sogenannten Makula, ermöglicht sie uns das scharfe Sehen, etwa beim Lesen oder Erkennen von Gesichtern. Kommt es hier zu Veränderungen, kann dies unser Sehen stark beeinflussen – so zum Beispiel bei der Bildung feiner Zellmembranen auf der Netzhautoberfläche.
Der zentrale Bereich der Makula wird als Fovea und der zentralste Bereich als Foveola bezeichnet. Nur mit diesem kleine Areal der Netzhaut können wir wirklisch scharf sehen. Eine epiretinale Gliose (andere Bezeichnungen: Zellophanmakulopathie, prämakuläre Fibrose oder Makular Pucker) ist eine Erkrankung des Auges, bei der eine dünne Bindegewebsmembran über die innere Oberfläche der Netzhaut wächst. Die durch das Wachstum der epiretinalen Membran hervorgerufenen Veränderungen führen zu Veränderungen in der Struktur der Netzhaut und folglich zu Veränderungen des Sehvermögens.
Da die Membran in der Regel über die Makula wächst, ist das zentrale Sehen oft beeinträchtigt. Was die Ursachen anbelangt, so können epiretinale Membranen idiopathischen Ursprungs sein (primär entstanden) oder sekundär, d. h. sie können als Folge anderer Augenkrankheiten entstehen. Idiopathische epiretinale Membranen sind die häufigste Form. Sekundäre epiretinale Membranen können als Ursachen haben:
Menschen, bei denen in der Vergangenheit eine epiretinale Membran in einem Auge aufgetreten ist, haben ein erhöhtes Risiko, die Krankheit auch im anderen Auge zu entwickeln. Es gibt keine vorbeugenden Maßnahmen für idiopathische epiretinale Membranen. Das Risiko, sekundäre epiretinale Membranen zu entwickeln, kann in einigen Fällen verringert werden, wenn die zugrundeliegende Ursache diagnostiziert und entsprechend behandelt wird. Beide Geschlechter sind gleichermaßen von dieser Pathologie betroffen.
Die Veränderung der Makula durch eine epiretinale Gliose kann folgende Symptome hervorrufen:
Primäre epiretinale Membranen sind häufig asymptomatisch. Mittels der optischen Kohärenztomographie (OCT) ist es möglich, die Schwere der anatomischen Veränderungen einzuschätzen.
Die Diagnose der epiretinalen Membran wird vom Augenarzt auf der Grundlage der Anamnese, der Fundusuntersuchung und möglicher diagnostischer Tests gestellt, wie z. B. der optischen Kohärenztomographie (OCT) oder der Fluoreszenzangiografie (FAG). Die FAG kann in Fällen einer sekundären epiretinalen Membran, einschließlich retinaler Gefäßverschlüsse oder diabtischer Gefäßveränderungen, nützlich sein, da sie auch die ggf. auslösende Ursache mit darstellt. Ein Makulaödem kann also durch eine Angiographie oder eine OCT bestätigt werden. Eine sorgfältige Untersuchung des Makulabereichs ist für die Beurteilung der epiretinalen Membran unerlässlich. Die Untersuchung des Glaskörpers, der Netzhautgefäße und der peripheren Netzhaut kann jedoch in sekundären Fällen Aufschluss über die Ursache der epiretinalen Membran geben.
Eine sorgfältige Untersuchung des anderen Auges ist ebenfalls obligatorisch, da epiretinale Membranen bei etwa 10-20 % der Patienten beidseitig auftreten. Die Symptome der epiretinalen Membran können je nach Stadium oder Entwicklung der Krankheit variieren. Die überwiegende Mehrheit der Patienten mit epiretinaler Membran sind in den frühen Stadien der Krankheit asymptomatisch. Die visuellen Symptome sind sehr variabel und manchmal unabhängig vom klinischen Schweregrad. Epiretinale Membranen sind in der Regel operativ behandelbar.
Die chirurgische Behandlung (Operation) zielt darauf ab, die Membran zu entfernen und so den Patienten ihr normales Sehvermögen zurückzugeben. Im Falle einer sekundären epiretinalen Membran muss gegebenfalls die zugrundeliegende Ursache im Rahmen der Operation mitbehandelt werden. Manchmal muss jedoch die auslösende Erkrankung vorab schon behandelt werden und erst dann kann die chirurgische Behandlung der Gliose durchgeführt werden. Bei der epiretinalen Membran wird eine Vitrektomie durchgeführt, bei der mittels spezieller Instrumente und eines Farbstoffes zur besseren Darstellung des erkrankten Gewebes die epiretinale Gliose schonend von der Netzhautoberfläche entfernt wird (Peeling). Zusätzliches Peeling der inneren Grenzschicht der Netzhaut (Lamina interna) beugt Rezidiven effektiv vor. Eine eventuelle Medikamentengabe am Ende des Eingriffs in den Glaskörperraum beschleunigt die Abheilung.
Die Verabreichung von antibiotischen und entzündungshemmenden Augentropfen sollte während der gesamten Erholungszeit (Dauer von 2-4 Wochen) beibehalten werden. Die Operationstechnik hat in den letzten Jahren große Fortschritte gemacht und Operationen wie diese gehören bei uns zur täglichen Routine. Die Heilungsschancen sind gut – fast immer lässt sich das Sehvermögen erhalten, in rund 90 % der Fälle nehmen die störenden Bildverzerrungen deutlich ab oder verschwinden und in ca. 2/3 der Fälle steigt auch die Sehschärfe wieder an.

Parkallee 301 28213 Bremen +49 (0)421 5665-200 info.bremen@bergmanclinics.de Mehr Informationen

Berner-Heerweg 173-175 22159 Hamburg-Farmsen +49 (0)40 645585-0 Mehr Informationen

Markt 10 21509 Glinde +49 (0)40 7111033 info.hamburg-glinde@bergmanclinics.de Mehr Informationen

Tonndorfer Hauptstr. 71 22045 Hamburg-Tonndorf +49 (0)40 3284063-5 Mehr Informationen

Hofgartenstraße 6 63739 Aschaffenburg +49 (0)6021 303-303 info.hof@bergmanclinics.de Mehr Informationen